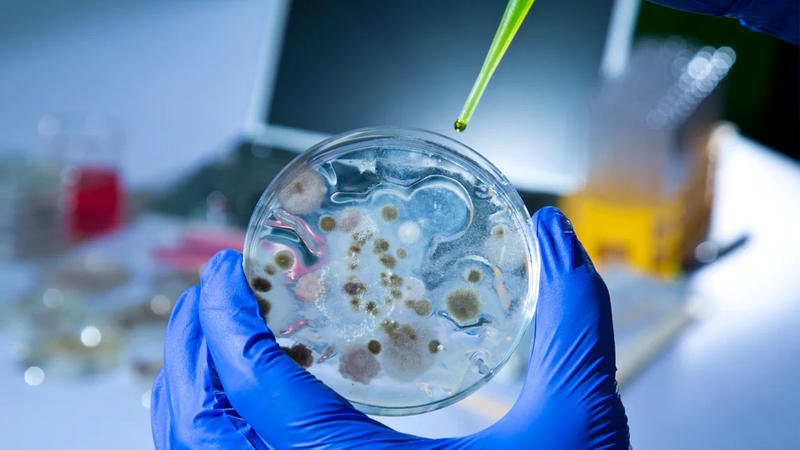
Củ sả: Dược liệu dễ tìm và đa công dụng 3

Dược sĩ Đại học có nhiều năm kinh nghiệm trong việc tư vấn Dược phẩm và hỗ trợ giải đáp thắc mắc về Bệnh học. Hiện đang là giảng viên cho Dược sĩ tại Nhà thuốc Long Châu.
Củ sả: Dược liệu dễ tìm và đa công dụng
Chí Doanh
04/04/2024
Mặc định
Lớn hơn
Củ sả là loại thảo dược được biết đến trên toàn thế giới vì hàm lượng tinh dầu cao. Chúng được phân phối rộng rãi trên tất cả các châu lục và được sử dụng cho nhiều mục đích khác nhau. Theo nghiên cứu khoa học, tinh dầu sả có khả năng kháng khuẩn, kháng nấm đáng kinh ngạc nhờ vào các thành phần hoá học có trong chúng. Bài viết dưới đây sẽ giới thiệu cho bạn một số thông tin cơ bản về loại cây này, các thành phần hóa học làm tính đa dụng của củ sả.
Nhiều liệu pháp thảo dược hiện đang được sử dụng rộng rãi trong y học. Việc sử dụng dược liệu làm thuốc chống viêm và giảm đau rất phổ biến trong hỗ trợ phòng COVID-19. Trong đó, củ sả là nguyên liệu được tiêu thụ nhiều nhất với công dụng đồn thổi là chống viêm, sát khuẩn, kháng virus. Thực hư ra sao về vấn đề này? Hãy cùng Long Châu tìm hiểu về sự đa công dụng của củ sả qua bài viết dưới đây.
Giới thiệu về củ sả
Sả là tên gọi chung của khoảng hơn 50 loại cây thơm thuộc chi Cymbopogon, họ Poaceae. Chúng là một loại cây thân thảo sống lâu năm, được trồng chủ yếu để lấy tinh dầu, phân bố rộng rãi ở các vùng nhiệt đới và cận nhiệt đới như Châu Phi, Châu Á và Châu Mỹ.
Chi này nổi tiếng với hàm lượng tinh dầu cao được sử dụng cho các ứng dụng mỹ phẩm, dược phẩm và nước hoa với hai loài chính là Cymbopogon flexuosus và Cymbopogon citratus. Nhưng Cymbopogon citratus lại được sử dụng nhiều hơn trong y học và ẩm thực. Chúng thường mọc thành bụi, có thân dày, dính bột sáp màu trắng; bẹ lá không có lông, lá nhọn, hẹp, dài 30 - 90 cm, rộng 5 - 15 mm, mép nhẵn hoặc nhám, có mùi thơm sảng khoái; hoa nhỏ màu xanh nhạt, mọc rải rác, ngọn rủ xuống.
Sả rất ưa ánh sáng, phát triển tốt ở điều kiện nhiệt độ cao, khí hậu mưa nhiều, chịu hạn tốt, không khắt khe với thổ nhưỡng, có thể sinh trưởng trên đất thịt pha cát, đất nâu đỏ và các loại đất khác.

Thành phần hóa học trong củ sả
Vì được sử dụng nhiều trong cuộc sống nên thành phần hóa học trong củ sả rất được quan tâm, chúng có chứa các hợp chất tự nhiên như alkaloid, terpenoid dễ bay hơi và không bay hơi, flavonoid, carotenoid và tannin,... Trong đó, flavonoid và terpenoid là hai hợp chất cho tác dụng y học nhiều nhất.
Flavonoid
Flavonoid là chất polyphenolic tự nhiên có đặc tính kháng viêm và chống oxy hóa mạnh nên có tác dụng bảo vệ chống lại các bệnh thoái hóa liên quan đến lão hóa như ung thư, tiểu đường và bệnh tim mạch, với các ứng dụng điều trị tiềm năng.
Terpenoid
Terpenoid không bay hơi
Thực vật thuộc chi Cymbopogon chứa một lượng lớn terpenoid dễ bay hơi như triterpenoid cymbopogone và cymbopogonol phân lập từ cây C. citratus.
Terpenoid dễ bay hơi
Củ sả chứa rất nhiều các hợp chất terpenoid dễ bay hơi khác nhau; trong đó, citral, geraniol, neral chiếm tỷ lệ cao nhất. Đặc biệt là citral - một thành phần chính có trong củ sả, đã được chứng minh là có tác dụng ức chế sản xuất interleukin trong các đại thực bào phế nang.
Củ sả có tác dụng gì?
Theo nhiều nghiên cứu khác nhau, tinh dầu sả đã được chứng minh là có những lợi ích sau.
Công dụng chữa bệnh của củ sả
Củ sả rất giàu vitamin A, C, E, folate, niacin và riboflavin, protein, chất chống oxy hóa và các chất dinh dưỡng khoáng chất. Theo y học hiện đại, củ sả có tiềm năng to lớn làm thực phẩm, dược phẩm, mỹ phẩm bao gồm:
Tiềm năng kháng khuẩn
Chiết xuất từ củ sả hay tinh dầu sả có hiệu quả chống lại nhiều loại vi khuẩn gây bệnh nhờ vào thành phần citral, geraniol. Nó được sử dụng như một chất kháng khuẩn (Escherichia coli, Klebsiella pneumoniae, Staphylococcus aureus) và kháng virus trong một số trường hợp, tùy vào nồng độ sử dụng mà có thể kìm hãm hoặc tiêu diệt vi sinh vật gây bệnh.
Tiềm năng kháng nấm
Các chất dễ bay hơi từ dầu sả, chẳng hạn như phenol, flavonoid và flavon, có hiệu quả chống lại nhiều chủng nấm gây bệnh trên người như Candida albicans và trên thực phẩm. Củ sả có thể duy trì hiệu quả chống lại sự sản sinh bào tử nấm trong thời gian dài, đảm bảo cải thiện thời hạn sử dụng cho các sản phẩm thực phẩm. Vì thế, sả được đề xuất trở thành một giải pháp thay thế bền vững trong ngành bảo quản và đóng gói thực phẩm nhằm ngăn chặn sự tấn công của nấm và hư hỏng thực phẩm thông qua việc hạn chế sự phát triển và sinh sản của nấm.
Tiềm năng kháng virus
Ngoài tác dụng diệt nấm và vi khuẩn, củ sả còn có hiệu quả chống lại nhiều loại vi rút ở các thử nghiệm trên động vật. Các nghiên cứu cho thấy củ sả có thể chống lại virus herpes simplex-I, mastadenovirus ở người - virus gây ra nhiều bệnh như nhiễm trùng đường hô hấp, viêm dạ dày ruột, viêm gan, viêm màng não, viêm phổi và nhiều bệnh khác. Chiết xuất sả cũng gây độc tế bào trong dòng tế bào ung thư biểu mô tuyến phổi ở người. Đặc biệt, trong đợt bùng phát đại dịch COVID những năm qua, hiệu quả của củ sả cũng được đề xuất để chống lại bệnh cúm và virus Corona SARS-CoV-2, đồng thời nâng cao mức độ liên quan và tầm quan trọng của tinh dầu sả.
Chống oxy hóa
Các gốc tự do quá mức trong cơ thể con người có thể gây ra các vấn đề như lão hóa, giảm khả năng miễn dịch, bệnh tim mạch, đột biến gen và ung thư. Sả chứa các chất chống oxy hóa thực vật có thể mang lại biện pháp bảo vệ tế bào và các cơ quan khỏi các loại oxy gốc tự do và giúp đẩy lùi stress oxy hóa.
Hỗ trợ chống ung thư
Trong số các terpenoid của của sả, citral có vai trò tiềm năng là chất chống tăng sinh một số loại tế bào ung thư, chẳng hạn như ung thư tuyến tiền liệt, ung thư buồng trứng, ung thư cổ tử cung và ung thư vú,... Và quan trọng là citral không gây độc tế bào đối với các tế bào biểu mô bình thường nhưng lại có tác dụng độc hại đối với các dòng tế bào ung thư ở người, xác nhận hiệu quả đặc hiệu đối với hỗ trợ chống bệnh ung thư.

Giảm cholesterol
Tinh dầu sả có khả năng hạn chế tích tụ chất béo, từ đó làm giảm cholesterol trong cơ thể và tránh các bệnh về tim như như huyết khối, xơ vữa động mạch và bệnh cơ tim thiếu máu cục bộ.
Giảm căng thẳng
Sả có mùi chanh nồng nàn, có thể nâng cao tinh thần và thư giãn. Có nghiên cứu cho thấy sả có thể kích hoạt hoạt động thần kinh giao cảm và giao cảm. Bạn có thể sử dụng máy khuếch tán tinh dầu trong nhà hoặc tại văn phòng làm việc để giúp bạn giảm stress, giảm mất ngủ và trầm cảm.

Giảm các triệu chứng cảm lạnh
Nhờ đặc tính kháng khuẩn, kháng nấm mạnh mẽ của sả giúp điều trị cảm lạnh, ho, cảm cúm, hen suyễn và bệnh viêm phế quản. Sả còn chứa vitamin A và C, giúp tăng cường hệ thống miễn dịch và ngăn ngừa cảm lạnh. Nếu vô tình bị cảm lạnh, hãy pha một ấm trà sả và gừng có thể giúp giảm nghẹt mũi và làm dịu cơn đau họng.
Vai trò khác của củ sả trong đời sống
Diệt côn trùng
Hoạt động diệt côn trùng là một trong những tác dụng sinh học của hầu hết các loài thực vật thuộc chi Cymbopogon. Nó được áp dụng như biện pháp kiểm soát dịch hại cho cây trồng được bảo quản hoặc làm thuốc đuổi muỗi, thuốc trừ sâu.
Gia vị
Sả là một nét đặc trưng của ẩm thực Đông Nam Á, có mùi thơm chanh mát lạnh, chủ yếu tạo thêm hương vị cho món ăn và thường thấy trong ẩm thực Thái Lan, Việt Nam, Ấn Độ. Khi sử dụng chủ yếu dùng để trộn với các loại gia vị khác để ướp thịt, hải sản,… hoặc làm món súp (như súp Tom Yum trong ẩm thực Thái Lan) để tiêu thụ, hoặc bẻ nhỏ và làm gia vị.
Khử mùi
Vì có mùi hương tươi mát nên sả được dùng trong xà phòng, nến, nước hoa và mỹ phẩm. Bạn có thể sử dụng các phương pháp tự nhiên để khử mùi tủ lạnh, máy giặt, máy rửa chén và các thiết bị gia dụng khác.

Loài Cymbopogon đã được sử dụng làm thuốc truyền thống ở nhiều nước. Trong số tất cả các loài được xem xét, C. citratus và C. flexuosus được sử dụng rộng rãi nhất trong Y học cổ truyền và thông thường do tiềm năng dược lý của các chất phytochemical của chúng. Phần lớn các loài này chứa một lượng lớn tinh dầu có nhiều hoạt tính sinh học như diệt côn trùng, chống động vật nguyên sinh, hỗ trợ tăng đề kháng chống ung thư, chống HIV, chống viêm và chống tiểu đường.
Xem thêm:
Có thể bạn quan tâm
Các bài viết liên quan
Bữa sáng nên chọn trứng hay sữa chua Hy Lạp để bổ sung protein?
Thức ăn chớm hỏng, đun sôi lại còn ăn được không?
Ngâm đậu nành quá lâu có tốt không? Lưu ý cần biết
Có nên mua máy làm sữa hạt? Ưu điểm và tiêu chí chọn mua cho gia đình
Cơm gà bao nhiêu calo? Ăn cơm gà có tăng cân không?
Sốt ăn sầu riêng được không? Những thông tin nên biết trước khi sử dụng
Mẻ là gì? Công dụng của mẻ trong chế biến thực phẩm
Người ốm có nên ăn mít không? Những lưu ý cần biết
Top 7 ngũ cốc nguyên hạt giúp cải thiện cholesterol và cách ăn phù hợp
Gợi ý những món hầm bổ dưỡng giúp bồi bổ sức khỏe
:format(webp)/Option_1_2_2d9677e5fd.png)
:format(webp)/Option_1_1_2a84e0cd00.png)
:format(webp)/ds_my_huyen_780f9bef46.png)